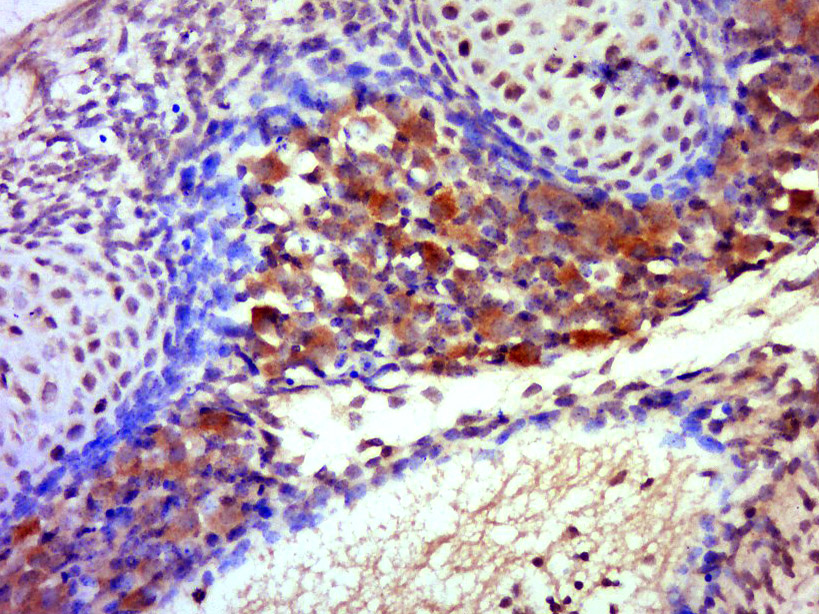
产品细节图片4

相关产品推荐更多 >

MUC1 Rabbit pAb, Biotin conjugated(bs-1018R-Bio)-100ul
¥2980
CK5+CK6 Rabbit pAb, HRP conjugated(bs-20824R-HRP)-100ul
¥2980
Newcastle disease virus Rabbit pAb(bs-4814R)-50ul/100ul/200ul
¥1180
Osteopontin Rabbit pAb, FITC conjugated(bs-23258R-FITC)-100ul
¥2980
NUMA1 Rabbit pAb(bs-3512R)-50ul/100ul/200ul
¥1180
万千商家帮你免费找货
0 人在求购买到急需产品
- 详细信息
- 文献和实验
- 技术资料
- 应用范围:
产品信息以Bioss网站为准
- 规格:
50ul/100ul/200ul
| 规格: | 50ul | 产品价格: | ¥1180.0 |
|---|---|---|---|
| 规格: | 100ul | 产品价格: | ¥1980.0 |
| 规格: | 200ul | 产品价格: | ¥2800.0 |
| 产品编号 | bs-0559R |
| 英文名称 | CDK5 Rabbit pAb |
| 中文名称 | 周期素依赖性激酶5抗体 |
| 英文别名 | Cdk 5; Cell division protein kinase 5; Crk6; Cyclin dependent kinase 5; Protein kinase CDK5 splicing; PSSALRE; Serine threonine protein kinase PSSALRE; Tau protein kinase II catalytic subunit; TPKII catalytic subunit; CDK5_HUMAN. |
| 产品应用 | WB=1:500-2000, IHC-P=1:100-500, IHC-F=1:100-500, IF=1:100-500, Flow-Cyt=1ug/Test Not yet tested in other applications. |
| 交叉反应 | Human, Mouse, Rat (Pig, Cow) |
| 抗体来源 | Rabbit |
| 免疫原 | KLH conjugated synthetic peptide derived from human CDK5 |
| 亚型 | IgG |
| 性状 | Liquid |
| 纯化方法 | affinity purified by Protein A |
| 克隆类型 | Polyclonal |
| 理论分子量 | 32 kDa |
| 浓度 | 1mg/ml |
| 储存液 | 0.01M TBS (pH7.4) with 1% BSA, 0.02% Proclin300 and 50% Glycerol. |
| 研究领域 | Cancer > Cell cycle > Cell division Cell Biology > Cell Cycle > Kinases/Phosphatases > Cdks Metabolism > Types of disease > Obesity Neuroscience > Neurology process > Neurogenesis |
| 亚基 | Heterodimer composed of a catalytic subunit CDK5 and a regulatory subunit CDK5R1 (p25) and macromolecular complex composed of at least CDK5, CDK5R1 (p35) and CDK5RAP1 or CDK5RAP2 or CDK5RAP3. Only the heterodimer shows kinase activity. Under neurotoxic stress and neuronal injury conditions, p35 is cleaved by calpain to generate p25 that hyperactivates CDK5, that becomes functionally disabled and often toxic. Found in a trimolecular complex with CABLES1 and ABL1. Interacts with CABLES1 and CABLES2. Interacts with AATK and GSTP1. Binds to HDAC1 when in complex with p25. Interaction with myristoylation p35 promotes CDK5 association with membranes. Both isoforms 1 and 2 interacts with beta-catenin/CTNNB1. Interacts with delta-catenin/CTNND2 and APEX1. Interacts with P53/TP53 in neurons. Interacts with EPHA4; may mediate the activation of NGEF by EPHA4. Interacts with PTK2/FAK1. |
| 亚细胞定位 | Isoform 1: Cytoplasm. Cell membrane; Peripheral membrane protein. Perikaryon. Cell projection, lamellipodium. Cell projection, growth cone. Cell junction, synapse, postsynaptic cell membrane, postsynaptic density. Note=In axonal growth cone with extension to the peripheral lamellipodia (By similarity). Under neurotoxic stress and neuronal injury conditions, CDK5R (p35) is cleaved by calpain to generate CDK5R1 (p25) in response to increased intracellular calcium. The elevated level of p25, when in complex with CDK5, leads to its subcellular misallocation as well as its hyperactivation. Co-localizes with CTNND2 in the cell body of neuronal cells, and with CTNNB1 in the cell-cell contacts and plasma membrane of undifferentiated and differentiated neuroblastoma cells. Reversibly attached to the plasma membrane in an inactive form when complexed to dephosphorylated p35 or CDK5R2 (p39), p35 phosphorylation releases this attachment and activates CDK5.
Isoform 2: Nucleus. |
| 组织特异性 | Isoform 1 is ubiquitously expressed. Accumulates in cortical neurons (at protein level). Isoform 2 has only been detected in testis, skeletal muscle, colon, bone marrow and ovary. |
| 翻译后修饰 | Phosphorylation on Tyr-15 by ABL1 and FYN, and on Ser-159 by casein kinase 1 promotes kinase activity. By contrast, phosphorylation at Thr-14 inhibits activity. |
| 相似性 | Belongs to the protein kinase superfamily. CMGC Ser/Thr protein kinase family. CDC2/CDKX subfamily.
Contains 1 protein kinase domain. |
| 功能 | Proline-directed serine/threonine-protein kinase essential for neuronal cell cycle arrest and differentiation and may be involved in apoptotic cell death in neuronal diseases by triggering abortive cell cycle re-entry. Interacts with D1 and D3-type G1 cyclins. Phosphorylates SRC, NOS3, VIM/vimentin, p35/CDK5R1, MEF2A, SIPA1L1, SH3GLB1, PXN, PAK1, MCAM/MUC18, SEPT5, SYN1, DNM1, AMPH, SYNJ1, CDK16, RAC1, RHOA, CDC42, TONEBP/NFAT5, MAPT/TAU, MAP1B, histone H1, p53/TP53, HDAC1, APEX1, PTK2/FAK1, huntingtin/HTT, ATM, MAP2, NEFH and NEFM. Regulates several neuronal development and physiological processes including neuronal survival, migration and differentiation, axonal and neurite growth, synaptogenesis, oligodendrocyte differentiation, synaptic plasticity and neurotransmission, by phosphorylating key proteins. Activated by interaction with CDK5R1 (p35) and ATP6V0D1 (p39), especially in post-mitotic neurons, and promotes CDK5R1 (p35) expression in an autostimulation loop. Phosphorylates many downstream substrates such as Rho and Ras family small GTPases (e.g. PAK1, RAC1, RHOA, CDC42) or microtubule-binding proteins (e.g. MAPT/TAU, MAP2, MAP1B), and modulates actin dynamics to regulate neurite growth and/or spine morphogenesis. Phosphorylates also exocytosis associated proteins such as MCAM/MUC18, SEPT5, SYN1, and CDK16/PCTAIRE1 as well as endocytosis associated proteins such as DNM1, AMPH and SYNJ1 at synaptic terminals. In the mature central nervous system (CNS), regulates neurotransmitter movements by phosphorylating substrates associated with neurotransmitter release and synapse plasticity; synaptic vesicle exocytosis, vesicles fusion with the presynaptic membrane, and endocytosis. Promotes cell survival by activating anti-apoptotic proteins BCL2 and STAT3, and negatively regulating of JNK3/MAPK10 activity. Phosphorylation of p53/TP53 in response to genotoxic and oxidative stresses enhances its stabilization by preventing ubiquitin ligase-mediated proteasomal degradation, and induces transactivation of p53/TP53 target genes, thus regulating apoptosis. Phosphorylation of p35/CDK5R1 enhances its stabilization by preventing calpain-mediated proteolysis producing p25/CDK5R1 and avoiding ubiquitin ligase-mediated proteasomal degradation. During aberrant cell-cycle activity and DNA damage, p25/CDK5 activity elicites cell-cycle activity and double-strand DNA breaks that precedes neuronal death by deregulating HDAC1. DNA damage triggered phosphorylation of huntingtin/HTT in nuclei of neurons protects neurons against polyglutamine expansion as well as DNA damage mediated toxicity. Phosphorylation of PXN reduces its interaction with PTK2/FAK1 in matrix-cell focal adhesions (MCFA) during oligodendrocytes (OLs) differentiation. Negative regulator of Wnt/beta-catenin signaling pathway. Activator of the GAIT (IFN-gamma-activated inhibitor of translation) pathway, which suppresses expression of a post-transcriptional regulon of proinflammatory genes in myeloid cells; phosphorylates the linker domain of glutamyl-prolyl tRNA synthetase (EPRS) in a IFN-gamma-dependent manner, the initial event in assembly of the GAIT complex. Phosphorylation of SH3GLB1 is required for autophagy induction in starved neurons. Phosphorylation of TONEBP/NFAT5 in response to osmotic stress mediates its rapid nuclear localization. MEF2 is inactivated by phosphorylation in nucleus in response to neurotoxin, thus leading to neuronal apoptosis. APEX1 AP-endodeoxyribonuclease is repressed by phosphorylation, resulting in accumulation of DNA damage and contributing to neuronal death. NOS3 phosphorylation down regulates NOS3-derived nitrite (NO) levels. SRC phosphorylation mediates its ubiquitin-dependent degradation and thus leads to cytoskeletal reorganization. May regulate endothelial cell migration and angiogenesis via the modulation of lamellipodia formation. Involved in dendritic spine morphogenesis by mediating the EFNA1-EPHA4 signaling. |
| 保存条件 | Shipped at 4℃. Store at -20℃ for one year. Avoid repeated freeze/thaw cycles. |
| 注意事项 | This product as supplied is intended for research use only, not for use in human, therapeutic or diagnostic applications. |
| 背景资料 | This gene encodes a proline-directed serine/threonine kinase that is a member of the cyclin-dependent kinase family of proteins. Unlike other members of the family, the protein encoded by this gene does not directly control cell cycle regulation. Instead the protein, which is predominantly expressed at high levels in mammalian postmitotic central nervous system neurons, functions in diverse processes such as synaptic plasticity and neuronal migration through phosphorylation of proteins required for cytoskeletal organization, endocytosis and exocytosis, and apoptosis. In humans, an allelic variant of the gene that results in undetectable levels of the protein has been associated with lethal autosomal recessive lissencephaly-7. Alternative splicing results in multiple transcript variants. [provided by RefSeq, May 2015] |
| 应用 | 推荐稀释比例 |
| {WB} | {1:500-2000} |
| {IHC-P} | {1:100-500} |
| {IHC-F} | {1:100-500} |
| {IF} | {1:100-500} |
| {Flow-Cyt} | {1ug/Test} |

Primary Antibody (green line): Rabbit Anti-CDK5 antibody (bs-0559R)
Dilution: 1μg /10^6 cells;
Isotype Control Antibody (orange line): Rabbit IgG .
Secondary Antibody (white blue line): Goat anti-rabbit IgG-AF647
Dilution: 1μg /test.
Protocol
The cells were fixed with 4% PFA (10min at room temperature)and then permeabilized with 90% ice-cold methanol for 20 min at room temperature. The cells were then incubated in 5%BSA to block non-specific protein-protein interactions for 30 min at room temperature .Cells stained with Primary Antibody for 30 min at room temperature. The secondary antibody used for 40 min at room temperature. Acquisition of 20,000 events was performed.

Antigen retrieval: citrate buffer ( 0.01M, pH 6.0 ), Boiling bathing for 15min; Block endogenous peroxidase by 3% Hydrogen peroxide for 30min; Blocking buffer (normal goat serum,C-0005) at 37℃ for 20 min;
Incubation: Anti-CDK5 Polyclonal Antibody, Unconjugated(bs-0559R) 1:300, overnight at 4°C, followed by conjugation to the secondary antibody(SP-0023) and DAB(C-0010) staining

Antigen retrieval: citrate buffer ( 0.01M, pH 6.0 ), Boiling bathing for 15min; Blocking buffer (normal goat serum,C-0005) at 37℃ for 20 min;
Incubation: Anti-CDK5 Polyclonal Antibody, Unconjugated(bs-0559R) 1:200, overnight at 4°C; The secondary antibody was Goat Anti-Rabbit IgG, Cy3 conjugated(bs-0295G-Cy3)used at 1:200 dilution for 40 minutes at 37°C.
Antigen retrieval: citrate buffer ( 0.01M, pH 6.0 ), Boiling bathing for 15min; Block endogenous peroxidase by 3% Hydrogen peroxide for 30min; Blocking buffer (normal goat serum,C-0005) at 37℃ for 20 min;
Incubation: Anti-CDK5 Polyclonal Antibody, Unconjugated(bs-0559R) 1:500, overnight at 4°C, followed by conjugation to the secondary antibody(SP-0023) and DAB(C-0010) staining

Lane 1: Large intestine (Mouse) Lysate at 40 ug
Lane 2: Large intestine (Rat) Lysate at 40 ug
Primary:
Anti-CDK5 (bs-0559R) at 1/1000 dilution
Secondary: IRDye800CW Goat Anti-Rabbit IgG at 1/20000 dilution
Predicted band size: 29 kD
Observed band size: 27 kD

风险提示:丁香通仅作为第三方平台,为商家信息发布提供平台空间。用户咨询产品时请注意保护个人信息及财产安全,合理判断,谨慎选购商品,商家和用户对交易行为负责。对于医疗器械类产品,请先查证核实企业经营资质和医疗器械产品注册证情况。
 文献和实验
文献和实验[IF={{ 4.53 }}] {Chernov AV et al. Amino acid sequence conservation of the algesic fragment of myelin basic protein is required for its interaction with CDK5 and function in pain. FEBS J. 2018 Sep;285(18):3485-3502. } {WB} {Rat}
[IF={{ 3.26 }}] {Yin, Xiang, et al. "Roscovitine treatment caused impairment of fertilizing ability in mice." Toxicology Letters (2015).} {WB} {="Mouse"}
[IF={{ 2.274 }}] {Wei Zhang. et al. FoxO1 overexpression reduces Aβ production and tau phosphorylation in vitro. Neurosci Lett. 2020 Nov;738:135322} {WB} {Mouse}
[IF={{ 12.067 }}] {Yang, Nanfei. et al. Blockage of PPARγ T166 phosphorylation enhances the inducibility of beige adipocytes and improves metabolic dysfunctions. CELL DEATH DIFFER. 2022 Nov;:1-13} {WB} {Mouse}
[IF={{ 1.93 }}] {Cao, Yu, et al. "Traditional Chinese Medicine Huannao Yicong Decoction Extract Decreases Tau Hyperphosphorylation in the Brain of Alzheimer’s Disease Model Rats Induced by Aβ1–42." Evidence-Based Complementary and Alternative Medicine 2016 (2016).} {IHC} {="Rat"}
= NAL), appears to form upon oxidative cyclization of the nonfluorescent 2:1 lysine-HNE Michael adduct-Schiff base cross-link (Scheme 1). Polyclonal antibody (PAb) to the NAL-HNE fluorophore was raised in rabbit and found to be highly specific
kinase assays toward cdk2, cdk5, and25 other kinases (23) . Currently thiadiazolidinone (TDZD) isthe only ATP-noncompetitive inhibitor of GSK-3 (24) . While theexact mechanism by which TDZD inhibits GSK-3 kinase activityis unclear, it has been suggested
GE Healthcare Benzamidine Sepharose™ 6B is p-aminobenzamidine covalently attached to Sepharose 6B by the epoxy coupling method. p-Aminobenzamidine (PAB), is a synthetic inhibitor of trypsin-like serine protease. Trypsin and trypsin
 技术资料
技术资料暂无技术资料 索取技术资料





